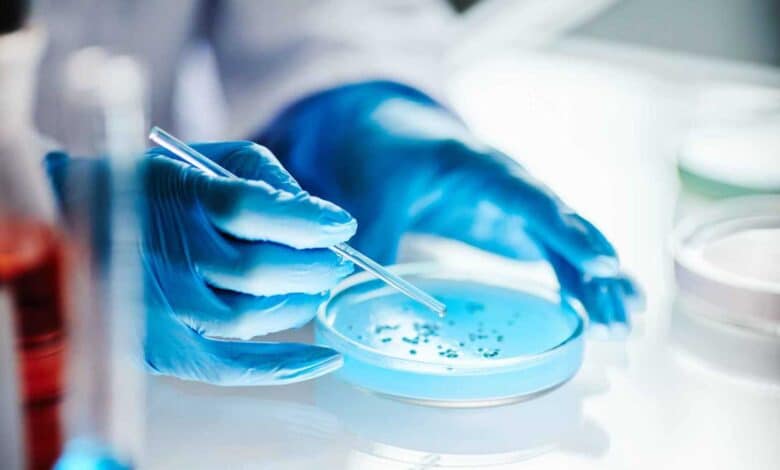

اكتشاف جيني جديد يفتح أفقًا لعلاج مرض ترنح فريدريك النادر
كشف علماء عن تغيرات جينية واعدة قد تمكّن الخلايا من أداء وظائفها الحيوية حتى في غياب بروتين “فراتاكسين”، البروتين المفقود لدى المصابين بـ مرض ترنح فريدريك، وهو اضطراب وراثي نادر وخطير يبدأ غالبًا في الطفولة أو المراهقة المبكرة، ويقصر متوسط العمر لدى الكثير من المصابين.
التقدم العلمي
أظهرت تجارب على الديدان، الخلايا البشرية، ونماذج الفئران أن خفض مستوى جين FDX2 يعيد نشاط إنتاج الطاقة داخل الخلايا، ما يفتح الباب أمام استراتيجية علاجية دقيقة ومبتكرة.
وتمكن فريق الباحثين من مستشفى ماساتشوستس العام، بريغهام، ومعهد برود من تحديد هذا التعديل الجيني كنقطة انطلاق محتملة لتطوير علاجات مستقبلية، ونُشرت نتائجهم في مجلة Nature.
كيفية الاكتشاف
استخدم العلماء ديدان C. elegans لفهم كيفية عمل الخلايا عند غياب بروتين فراتاكسين، مع وضع بعض الديدان في بيئات منخفضة الأكسجين لاختبار التغيرات الجينية. وبتحليل التسلسل الجيني، اكتشفوا طفرات في جيني FDX2 وNFS1 تساعد الخلايا على استعادة تكوين تجمعات الحديد والكبريت الضرورية لإنتاج الطاقة، حتى في غياب فراتاكسين.
النتائج واختبارات الفئران
أظهرت التجارب أن خفض مستويات FDX2 يحسّن صحة الخلايا، بينما يؤدي ارتفاعه إلى تعطيل هذه العملية الحيوية. وفي نموذج فأري للمرض، أدى خفض FDX2 إلى تحسن واضح في الأعراض العصبية، ما يعزز إمكانية تطوير علاج مستقبلي يعتمد على تعديل هذا الجين.
خطوة نحو العلاج المستقبلي
أكد الباحثون على أهمية تحقيق التوازن بين بروتين فراتاكسين وFDX2، مشددين على ضرورة إجراء المزيد من الدراسات لفهم هذا التوازن لدى البشر، بالإضافة إلى الدراسات ما قبل السريرية لتقييم سلامة وفعالية تعديل FDX2 قبل الانتقال لأي تجارب سريرية مستقبلية.



